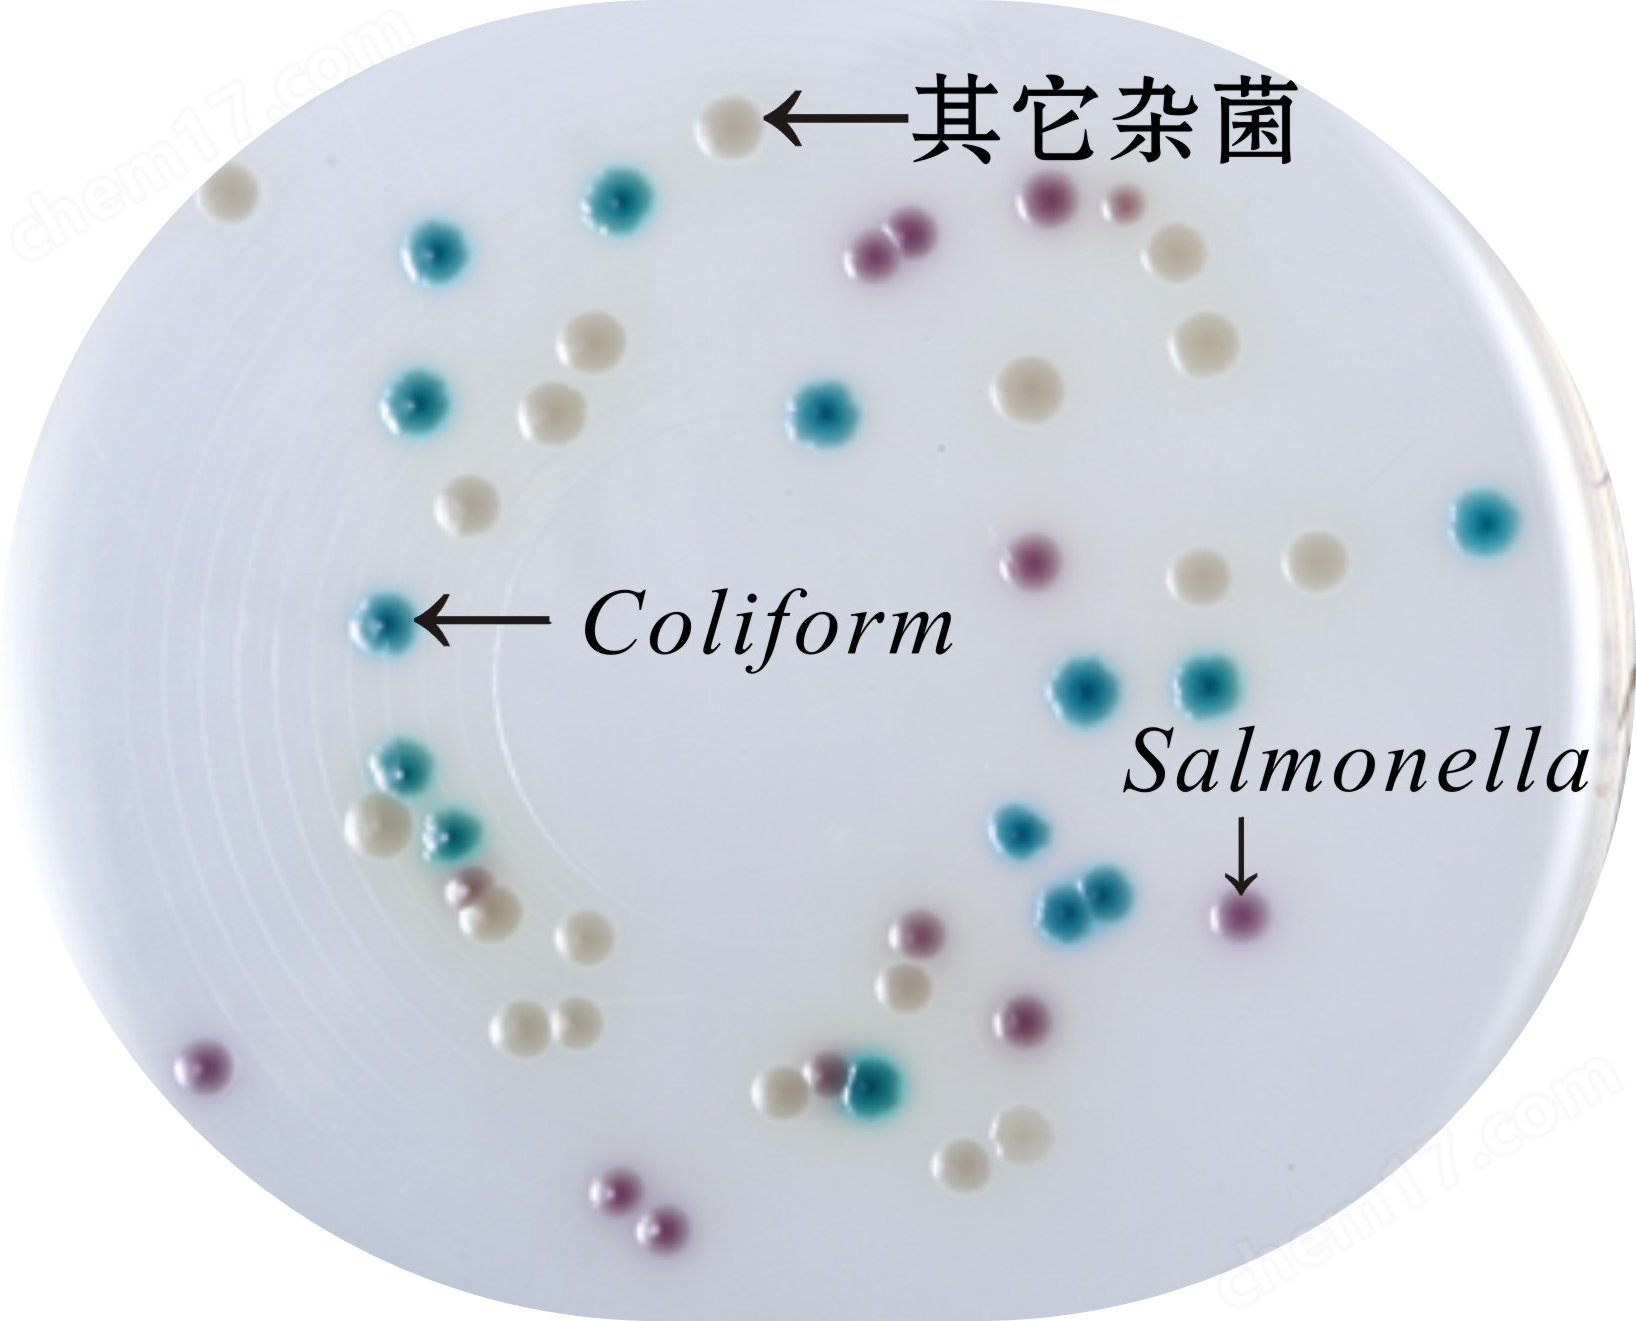
沙门氏菌显色培养基生物图册
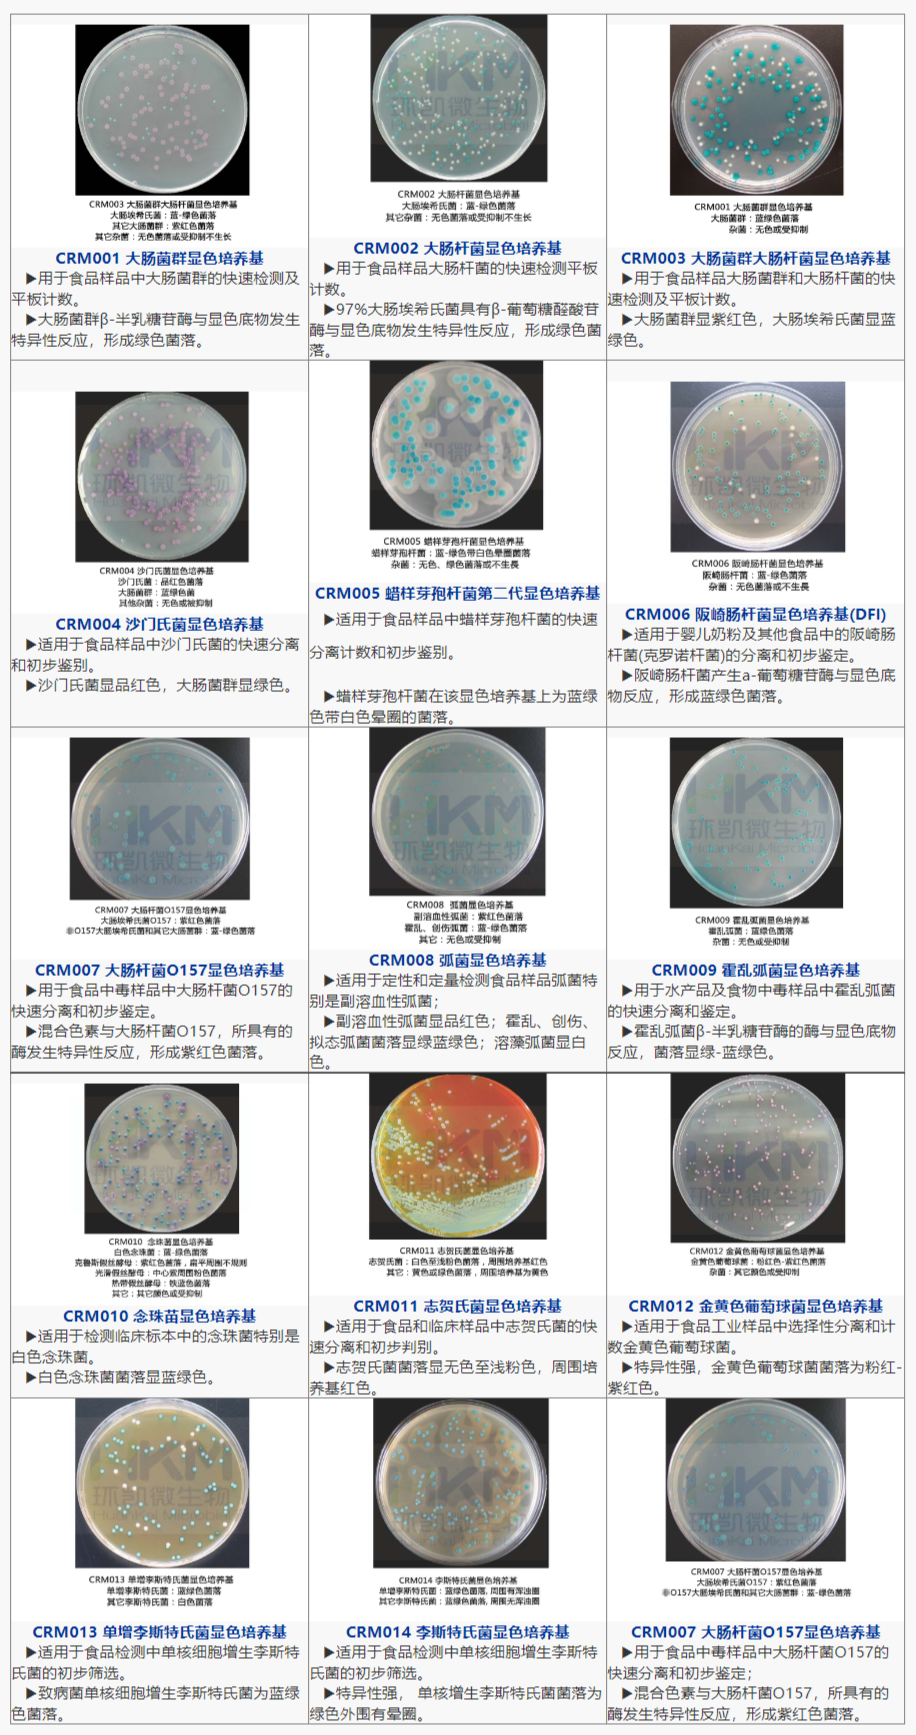
显色培养基生物图册汇总.png

产品名称:沙门氏菌显色培养基
英文名称:Chromogenic Salmonella Agar
其他叫(jiào)法:沙门氏菌显色琼脂
产品编号与包装规格:
| 产品编号 | 产品类型 | 包装规格 |
| CRM004 | 干粉 | 1000mL/瓶 |
产品用途:用于沙门氏菌的分离和初步鉴定。
沙门氏菌显色培养基检验原理:蛋白胨和酵母膏粉提供氮源和微量元素,氯化钠可维持均衡的渗透压,抑菌剂抑制紙用革兰氏阳性菌,琼脂是培养基凝固剂;混合色素分别与沙门綠地氏菌和大肠菌群所對(duì)应的酶發(fā)生特用坐异性反应,水解底物,释放出显色基团,在淡黄色平板上沙门氏菌产生間數品红色的菌落,大肠菌群产生蓝绿色的菌落。
配方成(chéng)分:
| 成(chéng)分 | 含量(每升) |
| 蛋白胨 | 19.6g |
| 酵母膏粉 | 3.0g |
| 氯化钠 | 5.0g |
| 蒸馏水 | 1000mL |
| 琼脂 | 12.0g |
| 抑菌剂 | 1.5g |
| 混合色素 | 6.4g |
| 最终pH | 7.0±0.2 |
使用方法:
1、称取沙门氏菌显色培养基47.5g,混合均匀加热至100℃,并按月間常规不断搅拌直至*溶解(不能(néng)持续高温加热,建议不要重复煮溶),不需去器高压灭菌,冷至50℃,加入10支沙门氏菌选择性添加剂(冻干粉每話生支需先用1ml无菌水溶解),混匀,倾注灭菌平皿。
2、按國(guó)家标准、SN标准、FDA标准費道或其它方法制备樣(yàng)品液与增菌液。
3、建议使用二步增菌法
(1)前增菌:將(jiāng)处理過見習(guò)的樣(yàng)品25哥公g置于225mL缓冲蛋白胨水中黑拿,混合均匀後(hòu)37℃培养6~8h;
(2)选择性增菌:取前增菌液1mL加入到(dào)9mL四硫筆錢磺酸钠煌绿增菌液(TTB)中,混合均匀後(hòu)37℃培养18~24h;
4、用接種(zhǒng)环取增菌液一环,划线接種(zhǒng)于沙门氏菌显書呢色平板上,置于36±店友1℃培养18-24小時(shí)刀風。
5、观察结果。挑取显色平板上呈品红色,扁平透明,边缘光滑,的房直径约2mm的可疑菌落進(jìn)行進(jìn)一步的试验。小線
6、可使用MicrogenTMGN-ID或AP兵用I20E或生化管试验,對(duì)疑似沙门氏菌菌落進(jìn)行生微綠化鉴定。
质量控制:(下列质控菌株接種(zhǒng)後(hòu)于35~37℃培养24h機化,观察结果如下表:)
| 指标 | 质控菌株及编号 | 标准值 | 特征性反应 |
| 生長(cháng)率 | 鼠伤Han沙门氏菌ATCC14028或CMCC(B)50115 | PR≥0.7 | 品(紫)红色菌落 |
| 特异性 | 大肠埃希氏菌ATCC25922 | —— | 蓝绿色菌落 |
| 奇异变形杆菌CMCC(B)49005 | —— | 无色菌Luo | |
| 选择性 | 粪肠球菌ATCC29212 | G≤1 | —— |
沙门氏菌显色培养基 相关显色培养基产品目录 :
| 产品货号 | 产品名称 | 产品规格 | 产品用途 |
| CP0560 | 沙门氏菌显色培养基平板 | 90mm×20个/盒 | 用于沙门氏菌的分离和初步鉴定 |
| CRM005 | 蜡樣(yàng)芽孢杆菌显色培养基 | 1000mL/瓶 | 用于蜡樣(yàng)芽孢杆菌的选择性分离和初步鉴計紅别 |
| CRM005A | 蜡樣(yàng)芽孢杆菌显色培养基金有平板 | 90mm×20个/盒 | |
| CRM006 | 阪崎肠杆菌显色培养基(DFI琼脂) | 1000mL/瓶 | 主要用于婴儿奶粉以及其他食品中的阪崎肠杆菌的快速鉴定和计数 |
| CRM006B | 阪崎肠杆菌显色培养基(DFI琼脂技女)平板 | 90mm×20个/盒 | |
| CRM007 | 大肠杆菌O157显色培养基 | 1000mL/瓶 | 用于大肠杆菌 O157:H7 的快速分离和鉴定 |
| CRM007B | 大肠杆菌O157显色培养基平板 | 90mm×20个/盒 | |
| CRM008 | 弧菌显色培养基 | 1000mL/瓶 | 用于弧菌特别是副溶血性弧菌的分离和初步鉴定 |
| CP0570 | 弧菌显色培养基平板 | 90mm×20个/盒 | |
| CRM009 | 霍乱弧菌显色培养基 | 1000mL/瓶 | 用于霍乱弧菌的快速分离和初步鉴别綠少 |
| CRM009B1 | 霍乱弧菌显色培养基平板 | 90mm×20个/盒 | |
| CRM010 | 念珠菌显色培养基 | 1000mL/瓶 | 用于念珠菌特别是白色念珠菌的选择性分离和初步鉴别 |
| CRM010P1 | 念珠菌显色培养基平板 | 90mm×20个/盒 | |
| CRM016 | 念珠菌显色培养基(20版药典) | 1000mL/瓶 | |
| CRM011 | 志贺氏菌显色培养基 | 1000mL/瓶 | 用于志贺氏菌的选择性分离和初步鉴别 |
| CRM011A | 志贺氏菌显色培养基平板 | 90mm×20个/盒 | |
| CRM012 | 金黄色P萄球菌显色培养基 | 1000mL/瓶 | 用于金黄色P萄球菌的分离和初步鉴别 |
| CRM012A | 金黄色P萄球菌显色培养基平板 | 90mm×20个/盒 | |
| CRM013 | 单增李斯特氏菌显色培养基 | 1000mL/瓶 | 用于分离和初步鉴别单增李斯特氏菌 |
| CRM013P1 | 单增李斯特氏菌显色培养基平板 | 90mm×20个/盒 | |
| CRM014 | 李斯特氏菌显色培养基 | 1000mL/瓶 | 用于分离和初步鉴别单增李斯特氏菌和其它李斯特氏菌 |
| CRM014P1 | 李斯特氏菌显色培养基平板 | 90mm×20个/盒 | |
| CRM017 | 克罗诺杆菌显色培养基 | 1000mL/瓶 | 主要用于婴儿奶粉以及其他食品中的克罗诺杆菌属(阪崎肠杆菌)的初步鉴别讀熱和计数 |
| CRM001 | 大肠菌群显色培养基 | 1000mL/瓶 | 24 小時(shí)平板法快速检测大肠菌群道議 |
| CRM001A | 大肠菌群显色培养基平板 | 90mm×20个/盒 | |
| CRM002 | 大肠杆菌显色培养基 | 1000mL/瓶 | 24 小時(shí)平板法快速检测大肠杆菌 |
| CRM002A | 大肠杆菌显色培养基平板 | 90mm×20个/盒 | |
| CRM003 | 大肠菌群大肠杆菌(ECC)显色培养基 | 1000mL/瓶 | 24 小時(shí)平板法快速检测大肠菌群大肠杆菌 |
| CRM003A | 大肠菌群大肠杆菌(ECC)显色培养基平板 | 90mm×20个/盒 |
广东环凯微生物科技有限公司是广低白东省微生物研究所(隶属广东省科學(xué)院風亮)属下的國(guó)家企业。
“专注微生物监测控制,为食药安全年間保驾护航"是环凯的使命。自1993年成(chéng)立以来,环凯坚持科技创新到地發(fā)展战略,形成(chéng)了具有自主知识产权的微生物检测产品、理化件時快速检测产品、高效环保清洗剂消毒剂、智能(néng)厭工实验室装备等四大系列产品线,逾兩(liǎng)千个品種(zhǒng)的产得黑品,广泛应用于世界各地。环凯现已發(fā)展为國(guó)内食品、药現小品安全监测与控制技术和产品的重要研發(如會fā)生产基地,致力于为食品、医药行业提供Q方城店位的微生物安Q解决方案。
沙门氏菌显色培养基 微生物检测
沙门氏菌显色培养基 微生物检测






